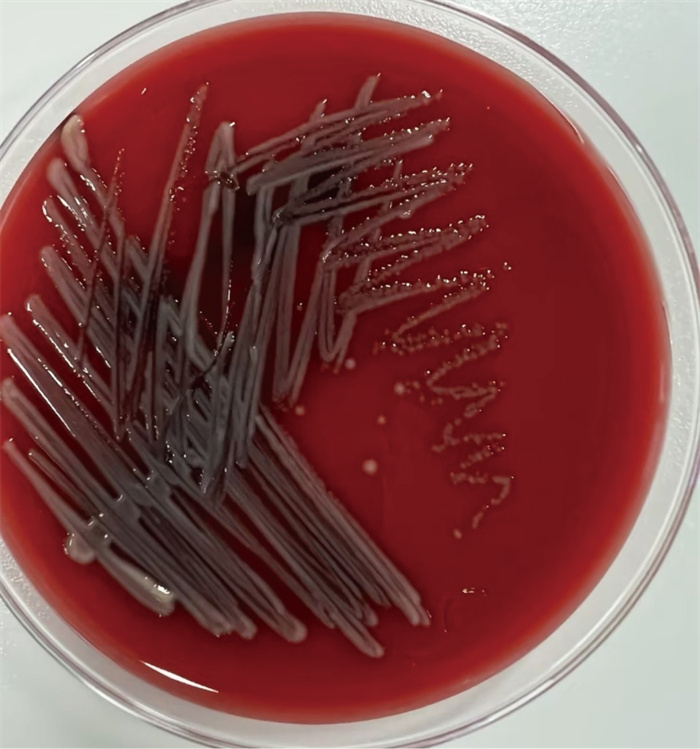

气单胞菌属细菌为革兰氏阴性菌,兼性厌氧杆菌。其引起的血流感染预后差[1]。临床上嗜水气单胞菌及豚鼠气单胞菌的相关报道较为常见,而达卡气单胞菌血流感染很少见。近年来,随着医疗技术的不断进步和临床研究的深入,国内外对气单胞菌属细菌感染的认识逐渐加深。然而,关于达卡气单胞菌血流感染的研究仍然相对较少,且主要集中在病原菌的鉴定方面。本文报告了一例肝硬化患者并发达卡气单胞菌血流感染的病例。
1 临床资料 1.1 病例资料患者,女,78岁。患者有原发性胆汁性肝硬化病史13年,既往反复住院治疗,近2年反复乏力、头晕、下肢水肿等不适。2023年7月27日,患者因腹胀、尿少2天就诊于肝胆外科,以肝硬化失代偿期收治入院。
既往史包括胆囊切除手术、心脏支架手术、高血压、桥本氏甲状腺炎伴甲状腺功能减退及胃底食管静脉曲张等。患者规律服用优甲乐治疗甲状腺功能减退。
入院时,患者呈营养不良、肝病面容,全身皮肤及巩膜明显黄染,腹膨隆,腹壁静脉曲张,脾脏肿大,移动性浊音阳性。专科检查未见其他异常。
1.2 诊疗经过2023年8月3日出现咽痛伴发热寒战情况,予以对症治疗后缓解,当晚出现右上肢肿胀伴皮下淤血,2023年8月4日出现左下肢较前肿胀明显,张力较前增高,皮温增高,触摸疼痛。同时24 h尿量明显减少,24 h尿量550 mL。体温38.9 ℃,脉搏89次/分,呼吸20次/分,血压133/57 mmHg,颜面水肿较前两日明显。实验室检查:血常规检查显示白细胞(white blood cell, WBC)减少(3.61×109/L)。炎症指标如C反应蛋白(C-reactive protein, CRP)(21.78 mg/L)和降钙素原(procalcitonin, PCT)(0.733 ng/mL)均升高。肝功能指标异常,总胆红素(total bilirubin, TBiL) (188.0 μ mol/L)显著升高,丙氨酸转氨酶(alanine transaminase, ALT) (53 U/L)和天冬氨酸转氨酶(aspartate transaminase, AST)(100 U/L)轻度升高。肌酸激酶(creatine kinase, CK)极高(>8 000 U/L)。肾功能指标如肌酐(creatinine, CREA) (145.1 μ mol/L)和尿素氮(urea nitrogen, UREA) (16.1 mmol/L) 均升高。当天抽取血培养单套双瓶报阳,涂片为革兰阴性杆菌,鉴定为气单胞菌属。予以美洛培南(1 g, q6h)抗感染经验治疗及血液净化清除炎症介质处理。而后患者出现蜂窝织炎、坏死性筋膜炎、横纹肌溶解及类似坏疽性深脓疱,并发生脓毒性休克。后根据药敏试验结果,给予患者注射美洛培南(1 g, q6h)+多西环素(100 mg, bid)+替考拉宁(0.2 g, qd)抗感染, 并同时进行给予患者补液、纠正凝血功能紊乱、升压等对症支持治疗。患者循环衰竭、多脏器功能衰竭仍进行性加重,于2023年8月6日死亡。
2 病原学检查及结果 2.1 菌落形态及生化结果患者2023年8月4日送检血培养,血培养5小时54分单套双瓶报告阳性,涂片为革兰氏阴性杆菌,细菌形态粗大(见图 1)。将报阳性结果的血培养瓶接种至血平板、麦康凯、巧克力,置于35 ℃、5% CO2温箱,经16小时培养,细菌形态湿润,有β溶血(见图 2);生化反应:氧化酶+、触媒+、纤维二糖+、VP-。

|
| 革兰氏阴性杆菌,形态粗大。 Gram negative bacilli with a stout morphology. 图 1 革兰氏染色镜下涂片(10×100) Fig. 1 Gram staining microscopic smear(10×100) |
|
| 形态湿润,有β溶血。 Moist in appearance with β hemolysis. 图 2 血平板菌落形态 Fig. 2 Colony morphology of blood plate |
梅里埃VITEK 2 Compact(上海生物梅里埃公司)鉴定为嗜水气单胞菌/豚鼠气单胞菌,挑取纯菌,用布鲁克质谱仪[布鲁克(北京)科技有限公司]对其进行鉴定,结果为嗜水气单胞菌(属内蛋白指纹图谱接近,与其他种不能区分)。为进一步明确此菌种种类,将菌株送至北京擎科生物科技有限公司进行16S rRNA及gyrB测序,返回结果在BLAST网站上比对,16S rRNA测序未能明确区分菌种,结果如表 1所示。gyrB测序将此菌鉴定为达卡气单胞菌(Aeromonas dhakensis),结果如表 2所示;通过病原宏基因组二代测序(metagenomics next-generation sequencing, mNGS)(委托广州金匙医学检验有限公司进行检测)将此菌株鉴定为达卡气单胞菌(鉴定置信度99%)。
| Description | Scientific name | Per.Ident (%) |
| Aeromonas dhakensis strain SA 16S rbosomal RNA gene, partial sequence | Aeromonas dhakensis | 100.00 |
| Aeromonas dhakensis strain VlTSMBJ1 16S ribosomal RNA gene, partial sequence | Aeromonas dhakensis | 100.00 |
| Aeromonas dhakensis strain 0Z-1 16S ribosomal RNA gene, partial sequence | Aeromonas dhakensis | 100.00 |
| Aeromonas caviae strain QW14 16S ribosomal RNA gene, partial sequence | Aeromonas caviae | 100.00 |
| Aeromonas caviae strain PaKu10 16S ribosomal RNA gene, partial sequence | Aeromonas caviae | 100.00 |
| Aeromonas caviae GSH8M-1 DNA, complete genome | Aeromonas caviae | 100.00 |
| Aeromonas caviae strain QSRB4 16S ribosomal RNA gene, partial sequence | Aeromonas caviae | 100.00 |
| Aeromonas hydrophila subsp, hydrophila JCM 3990 gene for 16S ribosomal RNA, partial seguence | Aeromonas hydrophila | 100.00 |
| Aeromonas dhakensis strain WW303 165 ribosomal RNA gene, partial sequence | Aeromonas dhakensis | 100.00 |
| Aeromonas ASNIH1 chromosome, comolete genome | Aeromonas ASNIH1 | 100.00 |
| Description | Scientific Name | Per.Ident (%) |
| Aeromonas dhakensis RYu-Ah62 DNA, complete genome | Aeromonas dhakensis | 99.81 |
| Aeromonas aquariorum strain A2-961203 DNA gyrase subunit beta (gyrB)gene, partial cds | Aeromonas dhakensis | 99.81 |
| Aeromonas dhakensis strain BC15 chromosome, complete genome | Aeromonas dhakensis | 99.71 |
| Aeromonas hydrophila subsp. dhakensis strain LMG 19564 DNA gyrase subunit beta (gyrB), gene.partial cds | Aeromonas dhakensis | 99.62 |
| Aeromonas sp MCCB 113 gyrase B (gyrB)gene, partial cds | Aeromonas sp MCCB 113 | 99.62 |
| Aeromonas sp MTHB gyrase B (gyrB)gene, partial cds | Aeromonas sp MTHB | 99.62 |
| Aeromonas sp MTHA gyrase B (gyrB)gene, partial cds | Aeromonas sp MTHA | 99.62 |
| Aeromonas hydrophila gyrB gene for DNA gyrase subunit beta, partial cds | Aeromonas hydrophila | 99.52 |
| Aeromonas hydrophila strain AN-2 GyrB (gyrB) gene, partial cds | Aeromonas hydrophila | 99.52 |
| Aeromonas dhakensis strain 1P11S3 DNA gyrase subunit B (gyrB)gene, partial cds | Aeromonas dhakensis | 99.52 |
使用BD革兰氏阴性药敏板在BD-Phoenix100系统(美国BD公司)上进行药敏试验,折点参考美国临床和实验室标准化协会(Clinical and Laboratory Standards Institute,CLSI)M45-A3文件[2],其药敏结果如表 3所示。该菌株对阿米卡星、氨曲南、氯霉素、头孢他啶、环丙沙星、头孢曲松、头孢吡肟、左氧氟沙星、复方新诺明、美洛培南、派拉西林/他唑巴坦及头孢呋辛敏感;对庆大霉素中介;对亚胺培南、四环素、厄他培南及头孢西丁耐药。根据药敏结果,本研究给予了针对性的抗生素治疗,但病情未见明显好转。
| 序号 | 抗生素 | 结果 | MIC(μg/mL) |
| 1 | 阿米卡星 | 敏感 | 16 |
| 2 | 氨曲南 | 敏感 | ≤2 |
| 3 | 氯霉素 | 敏感 | ≤4 |
| 4 | 头孢他啶 | 敏感 | ≤1 |
| 5 | 环丙沙星 | 敏感 | ≤0.5 |
| 6 | 头孢曲松 | 敏感 | ≤1 |
| 7 | 头孢吡肟 | 敏感 | ≤1 |
| 8 | 庆大霉素 | 中介 | 8 |
| 9 | 亚胺培南 | 耐药 | 8 |
| 10 | 左氧氟沙星 | 敏感 | ≤1 |
| 11 | 复方新诺明 | 敏感 | ≤1/19 |
| 12 | 美洛培南 | 敏感 | ≤0.125 |
| 13 | 四环素 | 耐药 | >8 |
| 14 | 派拉西林/他唑巴坦 | 敏感 | ≤4/4 |
| 15 | 厄他培南 | 耐药 | >2 |
| 16 | 头孢呋辛 | 敏感 | 8 |
| 17 | 头孢西丁 | 耐药 | >16 |
| 折点参照CLSI M45-A3气单胞菌属折点执行。MIC为最小抑菌浓度(minimal inhibitory concentration)。 | |||
气单胞菌属感染多发生于肠道内,通常属于自限性疾病,肠道外的血流感染大多发生在肝病或免疫力低下的患者中,并可并发坏死性筋膜炎[3]、脓毒血症休克甚至死亡[4]。气单胞菌属血流感染预后差,病死率高[1, 5-6]。临床血流感染病例多见嗜水气单胞菌及豚鼠气单胞菌,达卡气单胞菌血流感染报道则较少,但达卡气单胞菌细胞毒性更强[7]。本案例报告了1例由达卡气单胞菌引起的严重血流感染。患者于2023年8月3日开始出现发热等临床症状,进而出现蜂窝织炎、坏死性筋膜炎、横纹肌溶解及类似坏疽性深脓疱,并发生脓毒性休克,疾病进展非常迅速,即使及时采取抗生素治疗及消除炎症介质处理,患者仍然循环衰竭、多脏器功能衰竭进行性加重,于2023年8月6日死亡。
本病例中的达卡气单胞菌是一个较新的菌种,曾经被命名为嗜水气单胞菌达卡亚种和水族馆单胞菌,于2013年被正式统一命名为达卡气单胞菌[8]。达卡气单胞菌在临床上常被误鉴定为嗜水气单胞菌、维隆气单胞菌或豚鼠气胞菌[9],日本的一项研究指出,临床上此菌株感染并不少见,但其常被诊断为其他气单菌属感染[10]。传统的鉴定方法在达卡气单菌的鉴定上存在误差[11]。由于气单胞菌属内不同种间的蛋白指纹图谱非常接近,布鲁克质谱仪不能将其准确区分至具体的种别。相关研究提示,达卡气单胞菌属生化反应的不匹配率达50%[12]。本研究利用梅里埃的VITEK 2系统进行鉴定,结果提示本株菌可能是嗜水气单胞菌或豚鼠气单胞菌,同时,本研究进行了纤维二糖与VP试验,试验结果与达卡气单胞菌不相符。分子鉴定方面,16S rRNA测序显示其与多个菌种同源性得分相同(100%),也不能将其与气单胞菌属其他种进行区分。相关研究提示,用gyrB测序,可以将大部分气单胞菌鉴定到种[9-10, 13]。用gyrB测序此菌株排序第一的为达卡气单胞菌,其同源性得分达到99.81%,与其他菌种间有明显的区分。此外,本研究还进行了病原宏基因组学检测,结果亦提示此菌株为达卡气单胞菌,与gyrB测序结果相符。
达卡气单胞菌引起的血流感染症状严重,对其进行快速精准鉴定对于临床诊疗具有重要的价值,目前临床实验室常用的鉴定方法,如生化、质谱及16S rRNA均未能准确地将其鉴定到种,但gyrB测序、mNGS能将其与其他种进行很好的区分。因此,在日常的检验实践中,针对特殊疑难菌种的鉴定,可以综合使用多种鉴定方法,为临床提供一个精准的鉴定结果。
在经验性用药方面,气单胞菌对复方新诺明和第3代头孢菌素耐药较为严重,临床应慎重使用,气单胞菌科不同菌种对抗生素的耐药率存在差异[14],因此应根据药敏试验结果进行个体化治疗。在未获得药敏试验结果前,可根据当地流行病学资料及临床经验选择广谱抗生素进行经验性治疗,如阿米卡星、美洛培南等。然而,须注意的是,即使经验性治疗有效,也应待药敏结果出来后及时调整治疗方案,以避免耐药性的产生和传播。
| [1] |
杨香会, 付滕, 张海亚, 王彦丽, 李丽, 接贵涛. 急性白血病伴嗜水气单胞菌感染1例[J]. 中国感染与化疗杂志, 2023, 23(3): 376-378. [DOI]
|
| [2] |
Clinical Laboratory Standards Institute. Methods for antimicrobial dilution and disk susceptibility testing of infrequently isolated or fastidious bacteria, 3rd Edition, M45[S]. Wayne, PA: Clinical Laboratory Standards Institute, 2016.
|
| [3] |
Lai CC, Ding LW, Hsueh PR. Wound infection and septic shock due to Aeromonas trota in a patient with liver cirrhosis[J]. Clin Infect Dis, 2007, 44(11): 1523-1524.
[DOI]
|
| [4] |
裴文婧, 刘辉, 高磊, 胡昆, 郑凌, 叶静. 达卡气单胞菌致脓毒性休克一例并文献复习[J]. 中国呼吸与危重监护杂志, 2022, 21(11): 815-819. [DOI]
|
| [5] |
张雯霞, 陈君灏, 陈晨, 李玲霞, 张钰. 嗜水气单胞菌血流感染1例[J]. 中国感染与化疗杂志, 2020, 20(3): 328-330. [DOI]
|
| [6] |
Shizuma T, Tanaka C, Mori H, Fukuyama N. Investigation of bacteremia due to Aeromonas species and comparison with that due to enterobacteria in patients with liver cirrhosis[J]. Gastroenterol Res Pract, 2011, 930826.
[DOI]
|
| [7] |
渠凤甜, 周海健, 薛佳琦, 杜小莉, 胡锦瑞, 崔志刚, 谢桂林, 刘辰庚, 孟双. 虾源达卡气单胞菌全基因组分析和致病性研究[J]. 中国比较医学杂志, 2023, 33(3): 24-36. [DOI]
|
| [8] |
Beaz-Hidalgo R, Martínez-Murcia A, Figueras MJ. Reclassification of Aeromonas hydrophila subsp. dhakensis Huys et al. 2002 and Aeromonas aquariorum Martínez-Murcia et al. 2008 as Aeromonas dhakensis sp. nov. comb nov. and emendation of the species Aeromonas hydrophila [J]. Syst Appl Microbiol, 2013, 36(3): 171-176. [URI]
|
| [9] |
周妍妍, 南征, 闫东辉, 苏建荣. 3种方法鉴定气单胞菌临床分离株效果分析[J]. 疾病监测, 2019, 34(1): 70-75. [DOI]
|
| [10] |
Kitagawa H, Ohge H, Yu L, Kayama S, Hara T, Kashiyama S, Kajihara T, Hisatsune J, Sueda T, Sugai M. Aeromonas dhakensis is not a rare cause of Aeromonas bacteremia in Hiroshima, Japan[J]. J Infect Chemother, 2020, 26(2): 316-320.
[DOI]
|
| [11] |
Fernández-Bravo A, Figueras MJ. An update on the genus Aeromonas: taxonomy, epidemiology, and pathogenicity[J]. Microorganisms, 2020, 8(1): 129.
[DOI]
|
| [12] |
陈天楠, 胡鲲. 基于16S rRNA和gyrB基因串联DNA特征序列的气单胞菌鉴定方法[J]. 南方农业学报, 2023, 54(6): 1858-1867. |
| [13] |
贺桃凤, 李医, 陈晓, 陈瑜. 用gyrB、rpoD基因扩增测序进行气单胞菌分类的探讨[J]. 临床检验杂志, 2015, 33(8): 569-572. [DOI]
|
| [14] |
赫童, 杨双双, 邓铃俊, 严立, 张莉萍. 2010—2016年重庆一医院肠道外气单胞菌耐药性分析[J]. 中国感染与化疗杂志, 2017, 17(6): 653-657. |
 2024, Vol. 19
2024, Vol. 19


